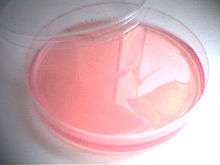

Endo agar
Endo agar
Endo agar (also called Endo's medium) is a microbiological growth medium with a faint pink colour.[1] Originally developed for the isolation of Salmonella typhi, it is now used mostly as a coliform medium. Most gram-negative organisms grow well in this medium, while growth of gram-positive organisms is inhibited.[2] Coliform organisms ferment the lactose in this medium, producing a green metallic sheen (i.e. Escherichia coli), whereas non-lactose-fermenting organisms produce clear, colourless colonies,[1] i.e. Salmonella sp..
Typical composition
Endo agar typically contains (w/v):[3]
- 1.0 % peptone
- 0.25 % dipotassium hydrogen phosphate (K2HPO4)
- 1.0 % lactose
- 0.33 % anhydrous sodium sulfite (Na2SO3)
- 0.03 % fuchsine
- 1.25 % agar
References
- 1 2 Mondofacto
- ↑ Becton, Dickinson and Company, , 2006
- ↑ EMD Chemicals, , 2002
| ||||||||||||||||||||||||||||||||||||||||||||
This article is issued from Wikipedia - version of the 4/27/2014. The text is available under the Creative Commons Attribution/Share Alike but additional terms may apply for the media files.